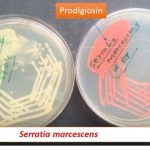
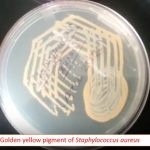
Golden yellow pigment of Staphylococcus aureus

Collection Group: Clinical Bacteriology
String Test: Principle, Procedure, Result and Interpretation
 String test to identify Vibrio cholerae Vibrio cholerae ( positive)...
String test to identify Vibrio cholerae Vibrio cholerae ( positive)...
Prodigiosin pigment of Serratia: Introduction, Pigment producing related bacteria and their significance
Pigment of Serratia marcescens Serratia has a good feature forming...
Pigment of Serratia marcescens Serratia has a good feature forming...
Golden yellow pigment of Staphylococcus aureus: Introduction and pathogenecity
Pigment of Staphylococcus Golden yellow pigment of Staphylococcus aureus which...
Pigment of Staphylococcus Golden yellow pigment of Staphylococcus aureus which...
